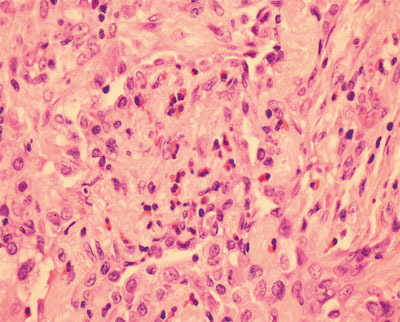
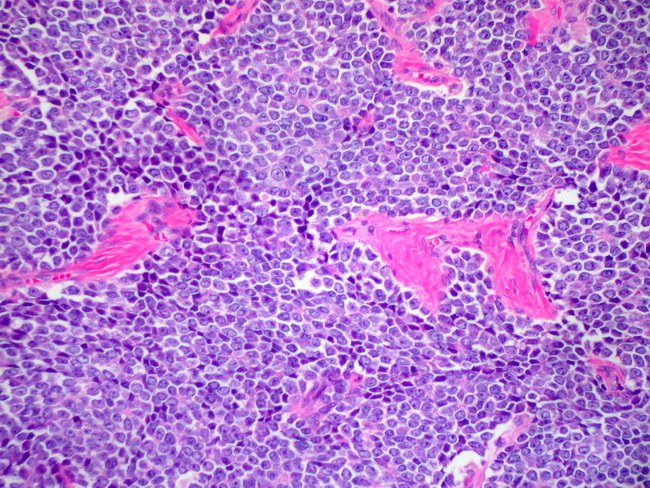
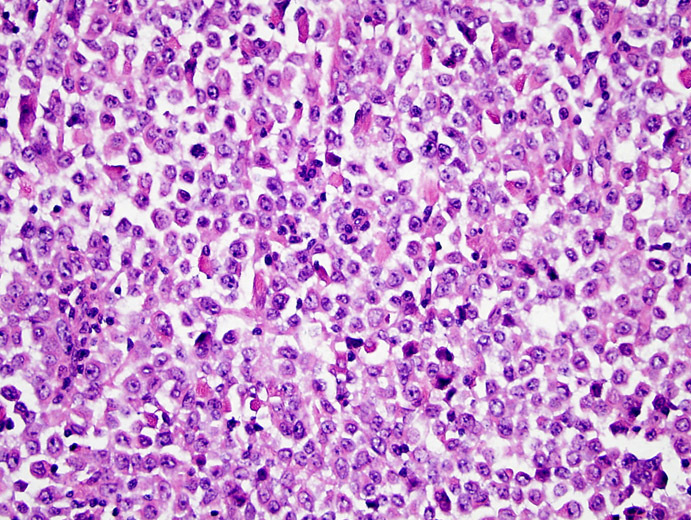

Diagnosis?
Inheritance pattern?
Gene?
Most common mutation?
Pathophysiology?
Symptoms?

Hereditary Hemochromatosis
Diagnosis?
2 types of bodies?
Most common?

Cardiac Sarcoidosis
Schaumann bodies are found with much higher frequency in sarcoidosis and berylliosis than in infective granulomatous diseases.
• Asteroid bodies are stellate inclusions that stain with antiubiquitin antibodies. They are less common than Schaumann bodies but do occur frequently.

Giant Cell Myocarditis v. Cardiac Sarcoid
Histiocytes?
Inflammatory cells?
Myocardium?
CD4/CD8?
Giant Cell Myocarditis
Cardiac Sarcoid

Diagnosis?
Symptoms?
Radiology?
Histology?
Causes?
Treatment?
Chronic eosinophilic pneumonia
Diagnosis?
Histology?
Age?
Prognosis?

Müllerian Adenosarcoma
Differential diagnosis of Ewing sarcoma?
Differential diagnosis of Ewing sarcoma
Diagnosis?
Genetic/molecular (most common}?
Stains?
Histology patterns?
Ewing sarcoma/PNET
Diagnosis?
Histology?
Stains?
Genetics?
Serum studies?

Neuroblastoma
Embryonal rhabdomyosarcoma

Mesenchymal chondrosarcoma

Acute atherothrombotic occlusion of the middle cerebral artery
Cerebral ischemic infarction
Cerebral ischemic infarction
Fanconi’s anemia
Fanconi’s anemia
Pap test in pregnancy
Pap test in pregnancy

Chondromyxoid fibroma

Common Variable Immunodeficiency (CVID)
Antibodies against M-type phospholipase A2 receptor (PLA2R) are central to the pathogenesis of?
Membranous Nephropathy
Most common PTLD T/natural killer (NK)-cell lymphomas?
Most common T/NK-cell posttransplant lymphoproliferative disorders (PTLD)

Congenital cystic adenomatoid malformation
Fire-Related Injuries
Fire-Related Injuries
Immunohistochemistry to Detect Transforming Mutations?
Immunohistochemistry to Detect Transforming Mutations
Luminal A/B tumors
Luminal A tumors
Luminal B tumors
Basallike breast cancers
Basallike breast cancers
HER2-positive tumors by gene expression profiling
HER2-positive tumors by gene expression profiling